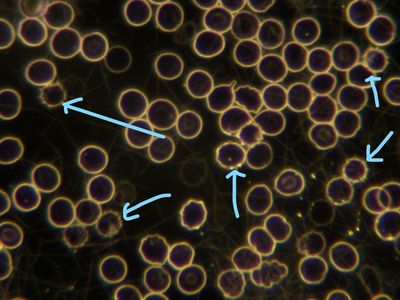
Detoxing (live blood analysis)

Signed in as:
filler@godaddy.com
Signed in as:
filler@godaddy.com
Most likely someone you know has recently been told by a medical professional that our bodies are capable of behaving randomly; or that their immune system may be attacking them; or even that a medically-inexplicable health problem may be 'all in their head.'
Don't allow yourself to get confused: Science is the 'guess, then test' process we use to attempt to understand how our world works. Just because we don't yet understand the effects we see does not mean our bodies aren't working hard and according to Nature.
This simple explanation of adding the lymph system to the human puzzle will take you less than 5 minutes and hopefully give you a life-changing A-Ha!
1) There are approximately 10 Trillion cells in our human body, each like a little factory. Each cell needs to be fed, do its job and eliminate its waste.
3) Cellular waste is incredibly caustic/burning - an estimated PH of 3. Our bodies are designed to usher it safely out through the lymphatic system: our sewer system composed of lymph fluid (cholesterol based), which acts like water in a toilet. The waste travels through lymph vessels, nodes, spleen and thymus...all the way out the kidneys and skin.
4) The lymphatic system doesn't have a pump. It relies on bodily movement!
5) If waste doesn't get eliminated through the lymph system, it begins to back up. We experience local effects wherever it gets stuck, such as head colds or stiffness in an armpit.
Inflammation (in-FLAME-ation) IS the burning sensation of these acids. (Example: muscle soreness, which we know as lactic acid backup.) It is the effect, most certainly not the cause!
6) If the waste continues to backup, we begin to feel (and be) increasingly ill. Soon the cells can't receive food and the waste gets so backed up that it doesn't even leave the cell. The 'factory' inside the cell gets damaged and begins to make new cells incorrectly.
7) At this point, things get complicated. Cells that can't get fed or heal themselves then die. (The medical profession coined a 'C' word for that. ) Waste, including dead cells, that can't get eliminated quickly enough through the lymph system may get stuffed away (tumors) to protect the body or sent directly out the skin though still a burning acid (psoriasis, for example). Brains get clogged; hearts get clogged; on and on. Organs with damaged cells begin to function incorrectly and that affects their interaction with other systems.
Fortunately, we can reverse this process through regenerative detoxification - unclogging the body through a return to a natural diet including botanicals that help clean, hydrate and strengthen the body.
- Lara Karakasevic, Founder
The Living Food Mission
Copyright © 2018-2025 The Living Food Mission - Regenerative Detoxification All Rights Reserved
